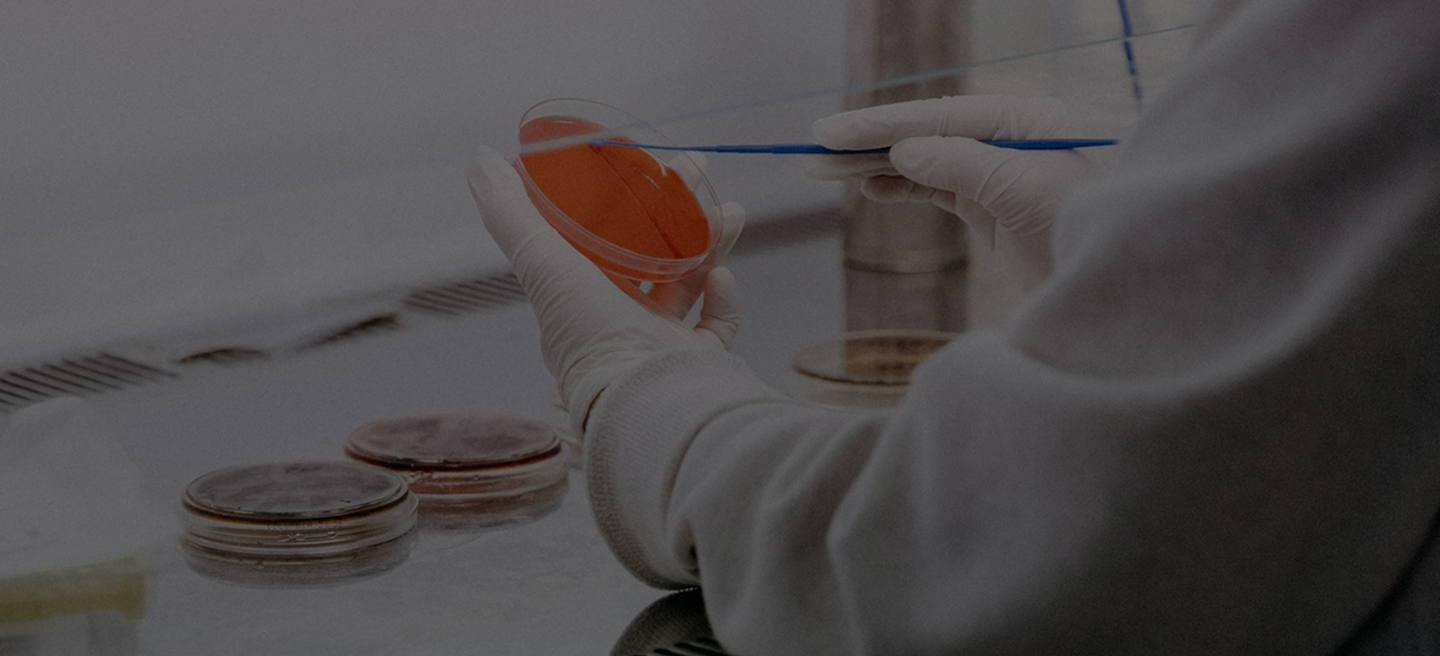

2025-2026 GRANTS CYCLE
Prospective Applicants:
The grants cycle is closed and 2026 awards will be announced this summer. Please stay tuned for details on the 2026-2027 cycle in the Fall.
———————
- Prospective applicants should click the link and follow the instructions to create a new account or log in.
- Prospective applicants will be routed directly to the LOI for PSC Partners & PSC Partners Canada Research Seed Grants.
- Make sure to press the SAVE button as you work on the LOI. The site does not auto-save.
- Questions about the program? Email grants@pscpartners.org
- Questions about technical issues with ProposalCentral? Emailpcsupport@altum.com
Please take a look at all the key application dates below.
If you have any questions, please contact grants@pscpartners.org.
PSC Partners and affiliate PSC Partners Canada award annual grants that drive research to identify treatments and a cure. Past studies have addressed an important and novel, basic, or clinical research question related to PSC and closely associated diseases (such as inflammatory bowel diseases and cholangiocarcinoma). Our Research Grants Program seeks to encourage investigators to conduct research in promising new areas, with the goal that data generated will lead to further seed funding from additional sources. We strongly encourage investigators to incorporate plans for patient partnership within their proposals. We are currently recruiting PSC patients, family members, or caregivers with scientific or clinical experience to become patient partnership representatives and grant reviewers. Investigators and community members can learn more here.
Award Amounts
PSC Partners awards two types of research grants:
- Research Seed Grant: Funding is limited to $37,500 per year for two years ($75,000 total)
- Young Investigator Award: Funding is limited to $50,000 per year for two years ($100,000 total)
2025-2026 Key Dates
August 18, 2025: Letter of Intent (LOI) Opens
December 1, 2025: Deadline to Submit LOI Form
February 1, 2026: Deadline to Submit Formal Grant Application
February & March 2026: Applications Reviewed By Scientific/Medical Advisory Committee (SMAC), Community Reviewers, Board of Directors of PSC Partners, and/or Board of Directors of PSC Partners Canada.
April or May 2026: Grant Awardees Announced
Who Can Apply?
To qualify for a Research Seed Grant, the primary investigator must:
- Have an advanced terminal degree (e.g., MD, PhD, or international equivalents) prior to the start of the grant period
- Be a researcher with preclinical (e.g., animal models, human tissue, organoids) and/or clinical (interventional, non-interventional, social sciences, etc.) expertise
- Be affiliated with an academic medical institution, research institution, or nonprofit/community-based organization
To qualify for the Young Investigator Award, the primary investigator must:
- Be in training or within five years of their last training position (e.g., residency, fellowship, post-doctoral fellowship) or degree (e.g., MD, PhD)
- Have completed an advanced terminal degree prior to the start of the grant period
- Be affiliated with an academic medical institution, research institution, or nonprofit/community-based organization
- Have a mentor or be willing to work with one if needed for the project
Additional Policies & FAQs
Are preclinical and clinical proposals both considered equally? We welcome basic science and clinical proposals. While all applications are reviewed using the same scoring criteria, PSC Partners reserves funding to select at least 1 clinical grant.
Are investigators required to incorporate patient partnership into their research proposal? Having a plan for patient partnership is strongly encouraged, as it can enhance the feasibility and impact of research. Patient partnership is one of the components that Community Reviewers evaluate while scoring applications. Even in basic science, patient partnership is possible. Learn more about incorporating patient partnership in your proposal, and contact grants@pscpartners.org for personalized guidance.
Are multiple investigators from the same institution allowed to apply? Grant selections are limited to 1 grant per department or division within the same institution. Multiple submissions from the same institution will be considered, with priority given to supporting a breadth of applicants from a variety of institutions.
Are past grantees of PSC Partners Research Grants Program allowed to reapply? If you have previously received a seed grant from us through the Research Grants Program, you can apply for funding again after a 1 year waiting period (i.e. 1 year after completion of the former 2 year grant period). The maximum amount of times an investigator can receive a grant through this program is 2 times within a 10 year period. These limits do not apply to investigators serving as co-investigators or as mentors for Young Investigators.
Can pharmaceutical, biotech, or related industries apply for startup funding? These companies are not eligible for funding through this program. Email research@pscpartners.org to learn about other potential research opportunities or partnerships.
How To Apply
All prospective applicants must submit the Letter of Intent Form.
- Upon submission, please allow approximately two weeks for the PSC Partners team to respond.
- If eligibility is determined, detailed application instructions will be provided to the applicant directly.
To request accommodations or inquire about this year’s grants process, please contact grants@pscpartners.org